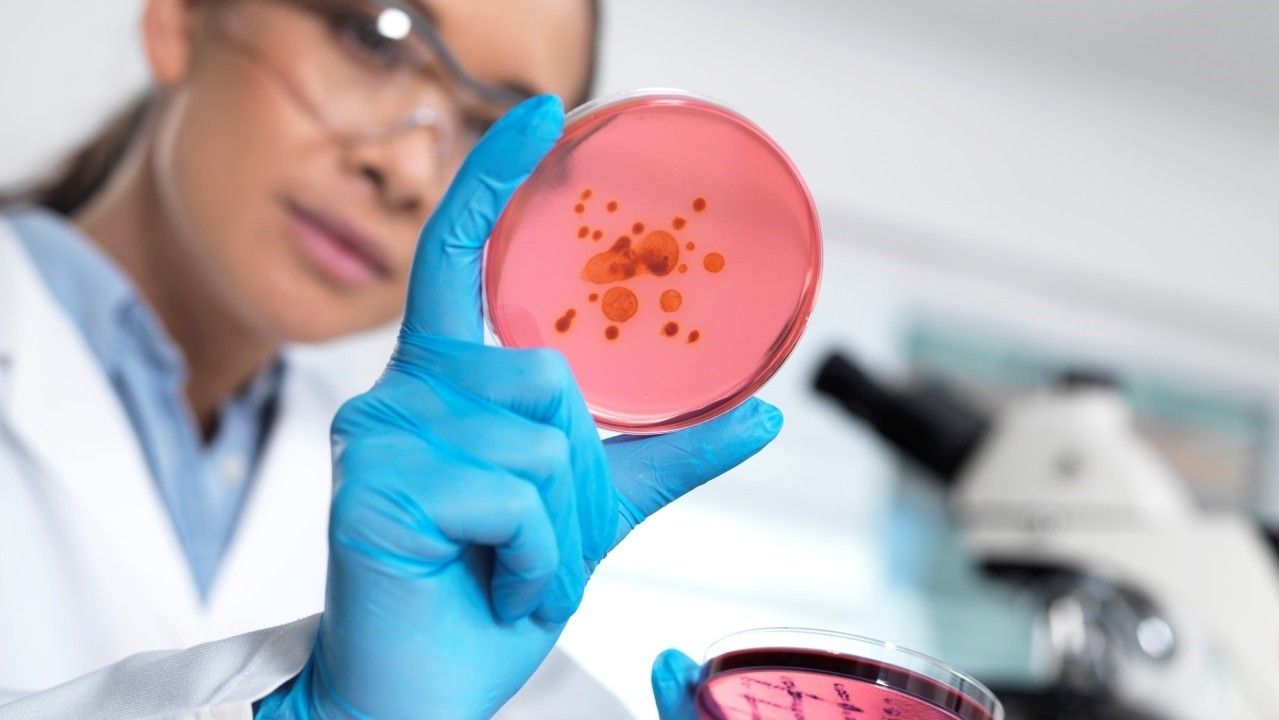
2024/01/159522950.jpg

Shkencëtarët kanë zbuluar një antibiotik të ri i cili synon të vrasë superbakterin vdekjeprurës
Shkencëtarët nga kompania farmaceutike Roche kanë zhvilluar një antibiotik të ri, zosurabalpin, i cili mund të kapërcejë rezistencën e superbakterit të njohur me emrin profesional Acinetobacter baumannii
Ky superbakter është identifikuar nga Organizata Botërore e Shëndetësisë si një kërcënim urgjent për të cilin nevojiten antibiotikë të rinj, pasi bakteri po përhapet me shpejtësi nëpër spitale dhe është rezistent ndaj trajtimeve ekzistuese.
Ekipi, i udhëhequr nga Michael Lobritz dhe Kenneth Bradley, kërkoi një bazë të dhënash me rreth 45,000 peptide sintetike, molekula që zakonisht nuk janë baza e shumicës së antibiotikëve, të marra nga natyra.
Midis tyre, ai identifikoi disa molekula me aktivitet antibakterial, ndër të cilat zgjodhi një, të cilën më pas e optimizoi për të përmirësuar efektivitetin dhe sigurinë e saj, transmeton Telegrafi.
Ilaçi, i cili tashmë ka shëruar minjtë nga pneumonia e shkaktuar nga A. baumannii, filloi të përdoret te njerëzit, në fazën e parë të provës, për të testuar sigurinë e tij në trajtimin e njerëzve.
Zosurabalpin kapërcen mbrojtjet që normalisht e bëjnë këtë bakter rezistent duke bllokuar transportin e molekulës, lipopolisakaridit, në sipërfaqen e baktereve, ku është e nevojshme të krijohet membrana e jashtme e këtyre mikroorganizmave.
Këtë e arrin duke kapërcyer vetëm njërën nga dy membranat që kanë bakteret gram-negative. Pa atë membranë të jashtme, ka më pak gjasa që A. baumannii mbijeton dhe bëhet i ndjeshëm ndaj antibiotikëve të tjerë.
Një studim i veçantë, i botuar gjithashtu në revistën Nature, shton informacione se si funksionon sistemi i transportit të lipopolisakarideve në sipërfaqen e qelizës për të krijuar membranën e jashtme dhe se si antibiotiku i ri e bllokon atë.
Kjo njohuri do të përdoret për të kërkuar komponime të reja që synojnë çaktivizimin e këtij mekanizmi dhe krijimin e mjeteve kundër rezistencës bakteriale, një problem që, sipas disa vlerësimeve, mund të jetë shkaku kryesor i vdekjes globale deri në vitin 2050. /Telegrafi/